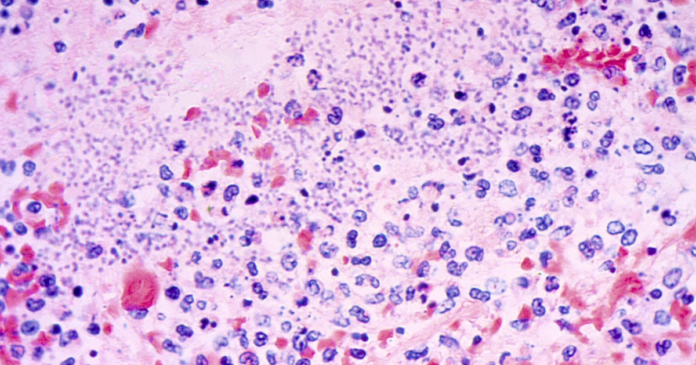

A resident of northern Arizona has died from pneumonic plague, health officials said Friday.
Plague is rare to humans, with on average about seven cases reported annually in the U.S., most of them in the western states, according to federal health of… [1961 chars]